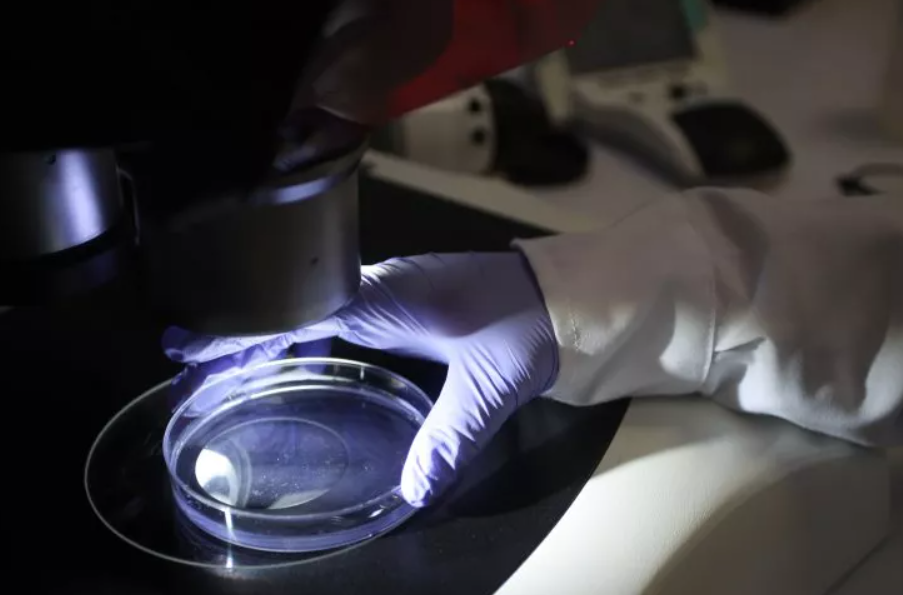
Yapay Zeka

Stanford ve Arc Enstitüsü’nde bilim insanları, bilgisayar başında oturan bir yapay zekanın sıfırdan yeni yaşam formları tasarlamasına tanıklık etti.
Bu kulağa bilim kurgu gibi gelebilir ama değil. Evo adı verilen yapay zeka sistemi, bakterileri öldürebilen bambaşka virüsler yarattı. Daha da çarpıcı olanı, bu virüslerin yalnızca dijital ortamda kalmayıp laboratuvarda gerçekten “hayata gözlerini açması.”
Evo, ChatGPT’nin metin yazarken yaptığına benzer bir şekilde çalışıyor; ancak kitaplarla değil, 2 milyon farklı virüs genomuyla eğitildi. Araştırmacılar ondan phiX174 adlı basit bir virüsün yeni versiyonlarını üretmesini istediklerinde, Evo tam 302 orijinal genetik tasarım ortaya koydu. Laboratuvar testlerinde bunlardan 16 tanesi gerçekten canlandı ve E. coli bakterilerini başarıyla enfekte etti. Projeyi yöneten Brian Hie, “Dijital kodun biyolojiye dönüşmesini görmek gibiydi,” diyerek tarihe geçen o anı tanımladı.
Potansiyel faydalar devasa. Her yıl yüzbinlerce can alan antibiyotik dirençli bakterilere karşı özel tasarlanmış virüs tedavileri, gelecekte hayat kurtarabilir. Yapay zeka sayesinde, yalnızca hedeflenen bakterilere saldıran “programlanmış virüsler” ya da genetik hastalıkları tedavi etmek için kullanılan mikroskobik gen taşıyıcıları tasarlamak mümkün olabilir.

Ama işin karanlık bir yüzü de var. Sentetik biyolojinin öncülerinden J. Craig Venter, bu teknolojiyi “deneme yanılmanın hızlandırılmış versiyonu” olarak nitelendirirken, aynı yöntemlerin çok daha tehlikeli patojenlerin geliştirilmesinde kullanılabileceği uyarısını yaptı. Evo’nun şu an yalnızca insana zararsız virüsler üzerinde eğitim aldığı doğru, ancak temel teknoloji yanlış ellere geçerse, tamamen başka amaçlara da yönlendirilebilir.
Bugün için Evo sadece küçük adımlar atıyor. Tüm bir hücreyi yapay zeka ile üretmek için milyonlarca genetik harf gerekiyor ve bu, virüslerden çok daha karmaşık bir görev. Yine de Ginkgo Bioworks gibi şirketler, tasarım aşamasından canlı organizmaya geçişi tamamen otomatikleştirecek sistemler üzerinde çalışıyor.
Dolayısıyla, bu gelişme yalnızca bir bilimsel başarı değil, aynı zamanda büyük bir dönüm noktası. Hayatın programlanabilir hale geldiği, biyoloji ile dijital kod arasındaki sınırların silinmeye başladığı bir çağın kapısı aralanıyor. Soru şu: Biz bu kapıdan geçmeye hazır mıyız?






